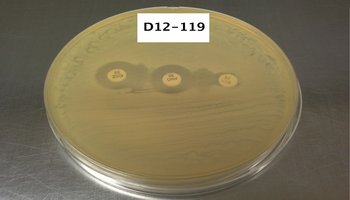

Philipp. Sci. Lett. 2014 7 (2) 438-444
available online: December 26, 2014
*Corresponding author
Email Address: cruz.merlyn@auf.edu.ph
Submitted: November 13, 2014
Revised: December 12, 2014
Accepted: December 12, 2014
Evaluation of extended-spectrum beta-lactamase production in Escherichia coli clinical isolates from three hospitals in Luzon, Philippines
© 2025 SciEnggJ
Philippine-American Academy of Science and Engineering